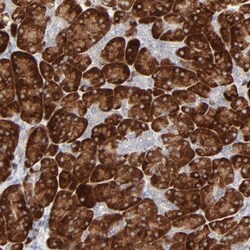
Invitrogen FANCB Polyclonal Antibody 100 &mu;L; Unconjugated:Antibodies,

missing translation for 'onlineSavingsMsg'
Learn More
Learn More
Invitrogen™ FANCB Polyclonal Antibody
Rabbit Polyclonal Antibody
Brand: Invitrogen™ PA551829
This item is not returnable.
View return policy
Description
Immunogen sequence: DSLNSDCLTS FKITDLGKIN YSSEPSDCNE DDLFEDKQEN RYLVVPPLET GLKVCFSSFR ELRQHLLLKE KIISKSYKAL INLVQGKDDN TSSAEEKECL VPLCGEEENS VHILDEKLSD NFQDSEQLVE KIWY Highest antigen sequence identity to the following orthologs: Mouse - 47%, Rat - 46%.
The Fanconi anemia complementation group (FANC) currently includes FANCA, FANCB, FANCC, FANCD1 (also called BRCA2), FANCD2, FANCE, FANCF, FANCG, FANCI, FANCJ (also called BRIP1), FANCL, FANCM and FANCN (also called PALB2). The previously defined group FANCH is the same as FANCA. Fanconi anemia is a genetically heterogeneous recessive disorder characterized by cytogenetic instability, hypersensitivity to DNA crosslinking agents, increased chromosomal breakage, and defective DNA repair. The members of the Fanconi anemia complementation group do not share sequence similarity; they are related by their assembly into a common nuclear protein complex. This gene encodes the protein for complementation group B. Alternative splicing results in two transcript variants encoding the same protein.
Specifications
| FANCB | |
| Polyclonal | |
| Unconjugated | |
| FANCB | |
| FA2; FAAP90; FAAP95; FAB; FACB; FANCB; Fanconi anemia complementation group B; Fanconi anemia group B protein; Fanconi anemia-associated polypeptide of 95 kDa; FLJ34064; Protein FACB | |
| Rabbit | |
| Antigen affinity chromatography | |
| RUO | |
| 2187 | |
| Store at 4°C short term. For long term storage, store at -20°C, avoiding freeze/thaw cycles. | |
| Liquid |
| Immunohistochemistry (Paraffin) | |
| 0.05 mg/mL | |
| PBS with 40% glycerol and 0.02% sodium azide; pH 7.2 | |
| Q8NB91 | |
| FANCB | |
| Recombinant protein corresponding to Human FANCB. Recombinant protein control fragment (Product #RP-92249). | |
| 100 μL | |
| Primary | |
| Human | |
| Antibody | |
| IgG |
Product Content Correction
Your input is important to us. Please complete this form to provide feedback related to the content on this product.
Product Title
Spot an opportunity for improvement?Share a Content Correction